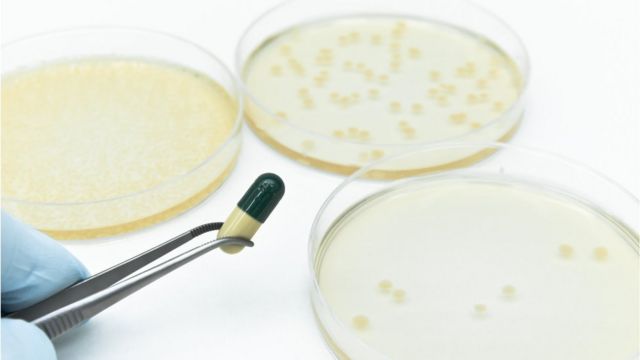

“وباء أشد فتكا من كورونا” يتوقع ان يتسبب في وفاة الملايين سنويا
شهارة نت – وكالات
تشير تقارير منظمة الصحة العالمية إلى أن استهلاك العالم من المضادات الحيوية شهد قفزة هائلة منذ بداية الألفية الثالثة؛ إذ رصدت المنظمة استخدام نحو 34.8 مليار جرعة من المضادات الحيوية كل عام، مع زيادة الاستهلاك العالمي بنسبة 65 في المائة بين عامي 2000 و2015.
وتعتبر المنظمة إساءة استعمال مضادات الميكروبات والإفراط في استعمالها المحركين الرئيسيين لظهور الميكروبات المقاومة للأدوية، والتي وصفتها المنظمة العالمية بأنها “وباء غير مرئي” قد يكون “أشد فتكاً على المدى الطويل من فيروس كورونا”؛ إذ يُتوقع أن تتسبب في وفاة نحو 10 ملايين شخص سنويا.
وتتمثل خطورة الإفراط في استخدام تلك العقاقير في أنها تسمح للبكتيريا والميكروبات بتطوير نفسها لتصبح مقاومة للمضادات الحيوية؛ إذ يموت نحو 700 ألف شخص في العالم، بينهم 300 ألف طفل حديث الولادة، كل عام، بسبب عدم فاعلية العقاقير المقاومة للالتهابات، وتشير التوقعات إلى أن الأرقام آخذة في الارتفاع.
وإذا كانت التقارير العالمية تشير إلى أن واحدا من كل خمسة مضادات حيوية تُوصف، في بريطانيا، وواحدا من بين كل ثلاثة مضادات تُوصف في الولايات المتحدة، دون داعٍ طبي؛ فإن الواقع في الدول العربية أكثر قتامة؛ إذ لا يتطلب الحصول على تلك العقاقير، في أغلب تلك البلدان، وصفة طبية.



